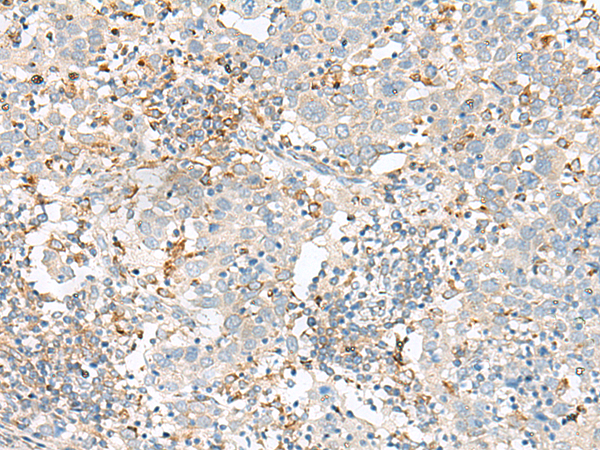
一抗

|
Background: |
SLC41A3 (solute carrier family 41 member 3) is a 507 amino acid multi-pass membrane protein that belongs to the SLC41A transporter family that includes SLC41A1 and SLC41A2. Localizing to the cell membrane, SLC41A3 contains ten transmembrane domains and is believed to function as a plasma-membrane cation transporter. Its other two family members, SLC41A1 and SLC41A2, have been characterized to function as magnesium transporters and are essential for maintaining magnesium homeostasis within the cell. |
|
Applications: |
ELISA, IHC |
|
Name of antibody: |
SLC41A3 |
|
Immunogen: |
Synthetic peptide of human SLC41A3 |
|
Full name: |
solute carrier family 41 member 3 |
|
Synonyms: |
SLC41A1-L2 |
|
SwissProt: |
Q96GZ6 |
|
ELISA Recommended dilution: |
5000-10000 |
|
IHC positive control: |
Human cervical cancer |
|
IHC Recommend dilution: |
30-150 |

 購物車
購物車 幫助
幫助
 021-54845833/15800441009
021-54845833/15800441009